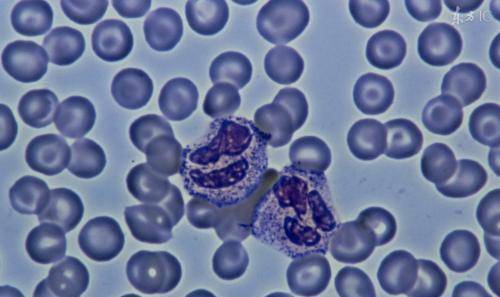
如何知道自己的体内有癌细胞 c2a1b256015f4284bb8e36d49e982703.jpeg

如何知道自己的体内有癌细胞
*** 次数:1999998 已用完,请联系开发者***

体内有癌,夜间知道?提醒:睡觉若有这4症状,或是癌细胞在叫嚣你知道吗?癌细胞或许能在你最安静的时刻发出信号,而这个信号,通常在你安睡的夜晚悄悄出现。 我们都知道,癌症的症状往往不容易察觉,特别... 自己这些年来因失眠而痛苦不堪,实际上就是癌症在发出警告,夜间的失眠,可能是癌细胞通过影响激素水平来改变体内的正常生物节律。 夜间突...

(`▽′) 癌细胞最喜欢的4种早餐,鸡蛋上榜!不想被癌盯上,管住嘴在忙碌的早晨,我们总是急于寻找一份简单快捷的早餐,但你知道吗?某些看似无害的早餐选择,可能正悄悄滋养着体内的癌细胞。今天,我们就来揭露癌细胞最喜欢的4种早餐,并告诉你如何做出更健康的选择。1. 甜面包与蛋糕:隐藏的“甜蜜杀手”早晨的面包摊上,甜面包和蛋糕总是散发着诱...

ˇ^ˇ 医生忠告:肺部有癌细胞的人,身上通常会有3个症状,千万别大意我们知道,肺部癌症往往被称为“沉默杀手”,它的潜伏性很强,很多时候,癌细胞已经在体内存在一段时间,但直到某个症状变得非常明显,才会被... 但最近几个月她却发现自己的声音越来越沙哑,而且这种沙哑并不伴随任何咳嗽或喉咙痛。 她一开始只是认为是因为日常说话多、工作环境干...

第528章 奇异的胳膊刘二狗现在需要将病人体内的癌细胞拔出来。 让玛丽苏亚看看,他是怎么样不开刀给病人做手术的。 虽然他知道这种方法治标不治本,但眼下也... 自己的胳膊都多半天了,竟然再没有疼过。 难道是那七道能量发生融合 ,不再开始反噬了。 刘二狗如是想着 ,心念一动 ,想要逼出一些能量,试试...
44岁演死亡戏算牺牲?她瞒癌痛拍完最后一镜,值吗?”没人知道那时癌细胞已在她体内疯狂扩散,更没人想到这场戏竟成了她人生的预演。 抗癌5年的朱媛媛刚走2个月,44岁的巨缘圣又倒下了 202... 社工小赵回忆:“她教我们怎么用肢体语言缓解病患疼痛,自己却疼得偷偷咬手腕。 ” 同行说她太较真:为演病人把自己饿脱相 《生命的感叹号...
>▂< 
体内有癌,睡觉先知?医生:冬天睡觉若有4症状,可能是癌的征兆癌症是一种逐渐侵蚀我们身体的慢性病,它往往在很长时间内没有明显的症状,因此早期发现成为了我们治疗成功的关键。 而你知道吗?我们的身体在睡觉时,竟然会给出一些潜在的信号,暗示着体内可能已经悄然生长出了癌细胞。人们常常忽视冬季睡觉时的身体变化,尤其是寒冷的气候会...
↓。υ。↓ 
∪ω∪ 体内有癌,淋巴先知?医生:淋巴结出现4种迹象,早去检查癌症,这个词常常让人心生恐惧,尤其是在日常生活中,我们经常听到各种关于癌症的新闻报道和故事。癌症的早期信号有很多,而淋巴结作为人体免疫系统的“哨兵”,在癌症的早期阶段常常会发出警告。你知道吗?淋巴结的变化可能是体内癌症的“先知”,它们会在癌细胞扩散之前,悄悄发...

第484章 炼气化神体内几乎已经检查不出癌细胞了。 因为黄一仙曾经救过王海的性命,龙五爷知道他医术高深,对他很是尊敬,对他所说的话也是深信不疑,听他这么... 这股力量就会成为自身气场的一部分,届时我也就拥有了堪比神龙的强大神力。 听了无尘子的解释,我不禁有些激动,忙问他怎么样才能使龙魂之...
∩△∩ 
飞飞加速器部分文章、数据、图片来自互联网,一切版权均归源网站或源作者所有。
如果侵犯了你的权益请来信告知删除。邮箱:xxxxxxx@qq.com
上一篇:如何知道自己的体内有癌细胞
下一篇:如何知道自己的体内有没有虫子





